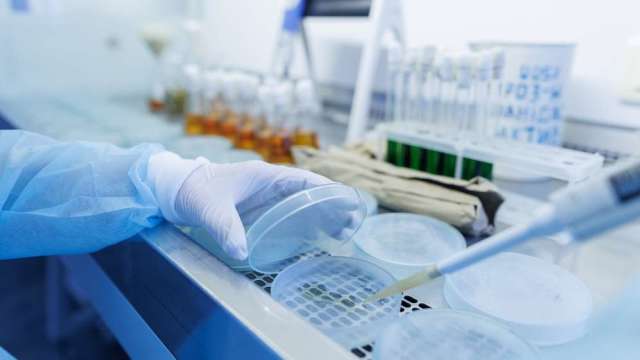

鉅亨網記者張韶雯 台北
KPMG 安侯建業與安侯法律事務所昨 (24) 日舉辦《2026 國內外法令展望研討會》,會中聚焦台灣 2026 年金融與產業法規的關鍵變革。本次研討會由安侯法律主持律師兼所長卓家立領銜,針對資產管理、再生醫療、AI 科技及虛擬資產等七大領域進行深度剖析。隨著行政院長卓榮泰積極推動台灣成為亞洲資產管理中心,各項配套法令正加速到位。
台灣金融監理制度持續朝國際化邁進,「亞洲資產管理中心高雄專區」試辦業務於 2025 年正式啟動,開放 38 項創新措施,涵蓋跨境推介、外部資產管理(EAM)、家族辦公室服務,以及另類基金多通路銷售等。同時鬆綁銀行、證券及投信投顧業務規範,允許跨業合作與更具彈性的財富管理模式。
安侯法律事務所合夥律師蘇瀚民指出,此舉展現台灣法規改革決心,主管機關已將家族辦公室納入試辦項目,並參考星、港立法例修正相關規範。預估至 2027 年,台灣高資產族群的私人財富規模將達新台幣 46 兆元,成為推動資產管理產業、鞏固台灣在亞洲金融市場地位的重要動能。
在企業全球布局方面,KPMG 畢馬威財務諮詢協理陳韋丞表示,2025 年在關稅與地緣政治風險持續升高的背景下,供應鏈重整已成為台商全球化策略的核心課題。由於建立當地營運與有效產能需時甚久,企業普遍轉向透過海外併購加速布局。然而,跨境併購除涉及關稅與採購層面的量化評估外,更牽動文化整合、當地團隊留任、跨境稅務規劃及金流安排等複雜議題,需仰賴企業內部團隊與外部專業顧問嚴密把關,方能確保交易安全並實現策略目標。
在生醫產業法規方面,安侯法律事務所資深律師蘇嘉瑞指出,「再生醫療法」與「再生醫療製劑條例」已於 2024 年 6 月完成立法院審議,相關施行細則預計將於 2026 年初正式上路。雙法不僅確保再生醫療的品質、安全與有效性,也將對外泌體開發、細胞儲存及細胞代工製造(CDMO)產業產生深遠影響。尤其如何銜接再生醫療雙法與「生技醫藥產業發展條例」之租稅優惠適用,是相關業者在進行法規遵循與投資評估時的重點。
針對不動產借名登記議題,安侯法律事務所合夥律師黃沛頌指出,借名登記在實務上長期存在,但法律風險日益增加。最高法院已明確否認以人頭方式取得原住民保留地之借名登記效力;近期法院實務亦就私有農地借名登記案例,認定若僅為規避非自耕農不得取得農地的規定,屬脫法行為而應屬無效。未來法院是否將更嚴格檢視因法令限制特定資格始得取得所有權的借名登記類型,並一概否認其效力,值得投資人持續觀察。
在科技監理趨勢上,KPMG 安侯企管數位創新服務副總林大中指出,AI 發展已從對話型應用,正式邁入具備決策與執行能力的「自主代理人(Agentic AI)」階段。當 AI 能自主調用工具時,將衍生越權執行與法律責任歸屬等新型治理風險,企業應及早建立管理與控管機制。此外,他也建議主管機關可評估研擬穩定幣試辦機制,涵蓋發行、流通至後端財稅處理的完整閉環,驗證法規相容性,讓虛擬資產服務能真正解決客戶痛點並創造商業價值。
虛擬資產與穩定幣的規範正成為全球監理重點。台灣目前正草擬虛擬資產服務法草案,立法後將大幅強化對穩定幣交易的保護機制,並開放企業在台灣發行穩定幣做為交易媒介。安侯法律事務所合夥律師鍾典晏表示,未來虛擬資產服務商須依項目取得主管機關許可,穩定幣發行人亦須設置足額準備資產並接受監督。新法推動將促使產業加速合規與市場重整,企業應及早強化內部機制並評估跨產業合作的可能性。
在財富傳承與反避稅議題上,安侯法律主持律師兼所長卓家立指出,財政部持續補充 CFC 與信託申報細節,顯示反避稅政策正加速落地。卓家立強調,有效的傳承不應僅從法律架構出發,而應先凝聚家族內部的共識與價值觀,再透過家族憲章、治理委員會與專業顧問制度加以落實。在快速變動的法規下,家族更應主動檢視整體傳承架構,避免消極仰賴境外受託機構的解釋,方能兼顧代際溝通與財富永續發展。
上一篇
下一篇